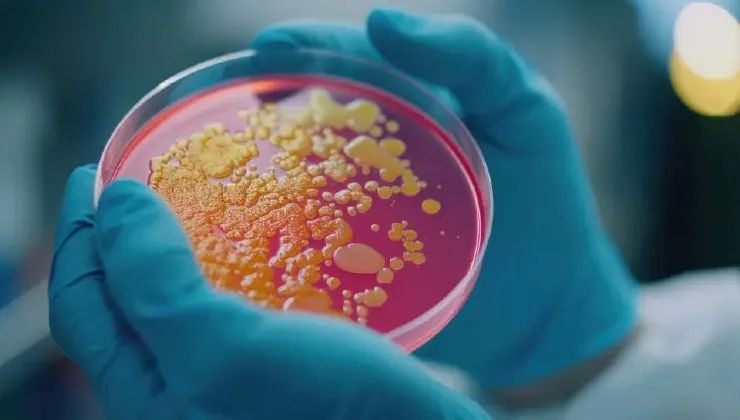

Clinica Ginecológica
Ginecología en Lima
Con más de 30 años de experiencia, en nuestra Clínica Ginecológica ofrecemos atención integral y personalizada, utilizando la más avanzada tecnología médica para cuidar de la salud femenina con profesionalismo, empatía y un enfoque en los últimos avances científicos, considerando el trato especial que toda mujer merece.
Experiencia
Satisfechos

Subespecialidades ginecológicas
Nuestra Clínica Ginecológica, cuenta con todas las subespecialidades ginecológicas para cuidar de tu salud femenina en cada etapa de la vida. Desde consultas preventivas hasta tratamientos avanzados, nuestros ginecólogos están preparados para ofrecerte una atención integral y personalizada. ¡Tu bienestar es nuestra prioridad!
Servicios de ginecología en lima
En nuestra Clínica Ginecológica en Lima, ofrecemos una amplia gama de servicios ginecológicos especializados para cuidar tu salud femenina en todas las etapas de la vida. Desde revisiones preventivas hasta tratamientos de alta complejidad, nuestros ginecólogos están comprometidos a brindarte una atención integral, profesional y personalizada. ¡Tu bienestar y confianza son nuestra principal prioridad!
Ginecólogos especialistas
Nuestra Clínica Ginecológica, cuenta con los mejores ginecólogos de Lima, profesionales altamente capacitados y comprometidos con tu bienestar. Con años de experiencia, brindan atención personalizada y de calidad para cuidar de tu salud femenina en cada etapa de tu vida. ¡Confía en nuestros ginecólogos especialistas!
La mejor clínica ginecológica en lima
Nos enorgullece ofrecer una atención excepcional respaldada por las experiencias de nuestras pacientes, quienes comparten su satisfacción con la calidad de nuestros servicios ginecológicos, el compromiso de nuestros ginecólogos y los resultados obtenidos en nuestra Clínica Ginecológica. Tu salud femenina es nuestra mayor prioridad, y cada testimonio refuerza nuestro compromiso con la excelencia.
Visita nuestra clínica ginecológica en san isidro, lima
¡Conoce nuestra Clínica Ginecológica, donde tu salud femenina es nuestra prioridad! Nos encontramos en San Isidro, Lima, Perú, comprometidos en brindarte atención especializada y tratamientos de vanguardia para tu bienestar. Visítanos y permite que cuidemos lo más importante: ¡Tu salud!
Blog de ginecología en lima
En nuestro Blog de Ginecología en Lima, encontrarás información actualizada y consejos prácticos sobre salud femenina. Desde cuidados preventivos hasta tratamientos innovadores, nuestro objetivo es brindarte el conocimiento necesario para cuidar de tu bienestar. ¡Mantente informada sobre lo último en ginecología!
agendar cita
Reserva tu cita ginecológica
Por favor, rellena este formulario. Nos pondremos en contacto contigo lo antes posible.
Todo sobre una clínica ginecológica
¿Qué es una clínica ginecológica y qué hace un ginecólogo o ginecóloga?
Una clínica ginecológica es un establecimiento de salud dedicado exclusivamente al cuidado del sistema reproductor femenino. A diferencia de otros centros médicos generales, una clínica de ginecología cuenta con especialistas altamente capacitados, como el ginecólogo o ginecóloga, quienes tienen la experiencia necesaria para diagnosticar, tratar y prevenir enfermedades ginecológicas.
El ginecólogo en Lima es el profesional encargado de evaluar la salud íntima de la mujer en todas las etapas de su vida, desde la adolescencia hasta la menopausia. Por su parte, una ginecóloga en Lima cumple el mismo rol, brindando atención médica especializada con un enfoque integral y personalizado, lo que muchas pacientes prefieren por comodidad y confianza.
Entre las principales funciones de un ginecólogo o ginecóloga se encuentran:
- Realizar consultas ginecológicas preventivas: Evaluaciones periódicas orientadas a mantener la salud íntima, detectar posibles alteraciones y resolver dudas sobre el bienestar ginecológico.
- Detectar enfermedades como infecciones, quistes, miomas o cáncer ginecológico: Diagnóstico oportuno de diversas patologías mediante evaluación clínica y apoyo de exámenes especializados.
- Indicar y evaluar exámenes como Papanicolaou, colposcopía o ecografías: Solicitud e interpretación de pruebas clave para la detección temprana de enfermedades y el seguimiento de la salud reproductiva.
- Brindar asesoría en métodos anticonceptivos: Orientación personalizada sobre opciones anticonceptivas según la edad, estilo de vida y necesidades de cada paciente.
- Controlar el embarazo dentro del área de gineco obstetricia: Seguimiento médico durante todas las etapas de la gestación para asegurar el bienestar de la madre y el bebé.
- Realizar procedimientos médicos y quirúrgicos cuando sea necesario: Intervenciones que pueden ir desde tratamientos ambulatorios hasta cirugías especializadas según el diagnóstico.
En una clínica ginecológica en Lima, el trabajo del ginecólogo o ginecóloga no solo se enfoca en tratar enfermedades, sino también en educar a la paciente sobre su salud, promoviendo la prevención y el diagnóstico temprano como pilares fundamentales de la ginecología moderna.
Diferencia entre una clínica ginecológica y un consultorio ginecológico
Muchas personas suelen confundir una clínica ginecológica con un consultorio ginecológico, pero existen diferencias importantes que influyen directamente en la calidad de la atención médica.
Un consultorio ginecológico suele ser un espacio donde un ginecólogo o ginecóloga realiza consultas básicas y controles generales. Si bien puede ofrecer una buena atención inicial, generalmente tiene limitaciones en cuanto a tecnología, exámenes especializados y capacidad para realizar procedimientos más complejos.
En cambio, una clínica ginecológica en Lima ofrece un servicio mucho más completo e integral. En este tipo de centros, las pacientes pueden acceder a:
- Evaluaciones médicas especializadas: Atención realizada por profesionales con experiencia en distintas áreas de la ginecología, permitiendo diagnósticos más precisos y personalizados.
- Exámenes ginecológicos avanzados: Pruebas específicas que permiten detectar enfermedades de manera temprana y dar seguimiento adecuado a la salud reproductiva.
- Equipos de diagnóstico de alta precisión: Tecnología moderna que mejora la exactitud en los resultados y facilita la detección de diversas patologías.
- Tratamientos médicos y quirúrgicos: Opciones terapéuticas que abarcan desde medicamentos hasta intervenciones quirúrgicas según la condición de la paciente.
- Atención por un equipo multidisciplinario de ginecólogos y ginecólogas en Lima: Trabajo conjunto de varios especialistas que garantiza un enfoque integral en cada caso.
Otra diferencia clave es la capacidad de resolución. En una clínica de ginecología, es posible realizar desde una simple consulta hasta procedimientos como biopsias, tratamientos para el virus del papiloma humano (VPH) o cirugías ginecológicas, todo en un mismo lugar.
Por ello, acudir a una clínica ginecológica en Lima brinda mayor seguridad, precisión en el diagnóstico y un tratamiento más completo, lo que resulta fundamental para el cuidado adecuado de la salud femenina.
¿Por qué es importante acudir a una clínica ginecológica en Lima?
Acudir a una clínica ginecológica en Lima es fundamental para mantener una buena salud femenina y prevenir enfermedades que pueden afectar la calidad de vida. Muchas patologías ginecológicas, como infecciones, alteraciones hormonales o incluso el cáncer ginecológico, pueden desarrollarse sin presentar síntomas evidentes en sus etapas iniciales.
Por esta razón, la evaluación periódica por parte de un ginecólogo o ginecóloga en Lima permite detectar cualquier problema a tiempo y establecer un tratamiento adecuado antes de que la condición avance.
Además, una clínica ginecológica ofrece acceso a exámenes especializados que no siempre están disponibles en otros centros de atención. Esto incluye estudios como el Papanicolaou, la colposcopía o las ecografías ginecológicas, fundamentales para un diagnóstico preciso.
Otro aspecto importante es el enfoque preventivo. En la ginecología en Lima, cada vez se prioriza más la prevención sobre el tratamiento, promoviendo controles regulares y educación en salud para evitar complicaciones futuras.
Finalmente, acudir a una clínica de ginecología también brinda tranquilidad a la paciente, ya que recibe atención profesional, personalizada y basada en evidencia médica, lo que garantiza un cuidado adecuado en todas las etapas de su vida.
¿Qué servicios ofrece una clínica ginecológica?
Una clínica ginecológica en Lima ofrece una amplia variedad de servicios orientados al cuidado integral de la salud femenina. Estos servicios están diseñados para cubrir todas las etapas de la vida de la mujer, desde la adolescencia hasta la menopausia, y son brindados por un ginecólogo o ginecóloga en Lima con formación especializada.
Entre los principales servicios que ofrece una clínica de ginecología se encuentran:
- Consulta ginecológica: Evaluación integral realizada por un ginecólogo o ginecóloga para prevenir, diagnosticar y tratar enfermedades.
- Control ginecológico preventivo: Seguimiento periódico para detectar alteraciones a tiempo.
- Gineco obstetricia: Control del embarazo, seguimiento prenatal y evaluación materno-fetal.
- Fertilidad y reproducción: Diagnóstico y tratamiento de problemas para concebir.
- Ginecología estética y regenerativa: Procedimientos orientados al bienestar íntimo femenino.
- Ginecología oncológica: Diagnóstico y manejo de enfermedades como cáncer de cuello uterino, ovario o endometrio.
- Cirugías ginecológicas: Procedimientos mínimamente invasivos y quirúrgicos especializados.
En una clínica ginecológica en Lima, estos servicios se integran con tecnología moderna y protocolos actualizados, lo que permite ofrecer una atención segura, precisa y personalizada. Además, el enfoque integral de la ginecología en Lima garantiza que cada paciente reciba un tratamiento adecuado según sus necesidades específicas.
¿Qué exámenes se realizan en una clínica ginecológica?
Los exámenes realizados en una clínica ginecológica son fundamentales para evaluar el estado de salud del sistema reproductor femenino y detectar enfermedades en etapas tempranas. Un ginecólogo en Lima utiliza estos estudios para obtener un diagnóstico preciso y definir el tratamiento más adecuado.
Entre los principales exámenes ginecológicos se encuentran:
- Papanicolaou (Pap): Detecta cambios en el cuello uterino y permite prevenir el cáncer cervical mediante la identificación temprana de células anormales.
- Colposcopía: Estudio detallado del cuello uterino que permite identificar lesiones, inflamaciones o infecciones con mayor precisión.
- Ecografías ginecológicas: Permiten visualizar el útero, ovarios y otras estructuras internas, ayudando a detectar quistes, miomas u otras alteraciones.
- Histerosonografía: Evalúa la cavidad uterina con mayor precisión mediante el uso de solución salina, facilitando la detección de pólipos o anomalías.
- Tipificación de VPH: Identifica la presencia del virus del papiloma humano y determina los tipos de alto riesgo asociados al cáncer cervical.
- Cultivo de secreción vaginal: Detecta infecciones bacterianas, micóticas o parasitarias, permitiendo indicar el tratamiento adecuado.
- Biopsias ginecológicas: Permiten analizar tejidos en laboratorio para confirmar diagnósticos y descartar enfermedades como el cáncer.
Realizar estos exámenes en una clínica ginecológica en Lima garantiza mayor precisión, ya que se cuenta con equipos especializados y la supervisión de un ginecólogo o ginecóloga en Lima. Además, estos estudios forman parte esencial del chequeo ginecológico preventivo.
¿Qué enfermedades trata un ginecólogo o ginecóloga?
Un ginecólogo o ginecóloga en una clínica ginecológica en Lima está capacitado para diagnosticar y tratar una amplia variedad de enfermedades que afectan la salud femenina.
Entre las principales patologías que se atienden en la ginecología en Lima se encuentran:
- Infecciones vaginales (hongos, bacterias, ETS): Diagnóstico y tratamiento de alteraciones comunes que provocan flujo anormal, picazón o mal olor, asegurando recuperación y prevención de recurrencias.
- Virus del papiloma humano (VPH): Identificación de la infección, seguimiento y prevención de lesiones precancerosas y cáncer cervical.
- Quistes ováricos: Evaluación de formaciones en los ovarios, determinando si requieren control periódico o intervención quirúrgica.
- Miomas uterinos: Detección de tumores benignos que pueden causar dolor, sangrado o dificultades reproductivas, con tratamiento personalizado.
- Endometriosis: Evaluación del crecimiento de tejido endometrial fuera del útero, manejo del dolor pélvico y posibles problemas de fertilidad.
- Trastornos hormonales: Detección de desequilibrios que afectan el ciclo menstrual, fertilidad y bienestar general de la paciente.
- Sangrados uterinos anormales: Identificación de causas de sangrado irregular, abundante o fuera del ciclo, con tratamiento adecuado.
- Infertilidad: Análisis integral de dificultades para concebir y planificación de estrategias médicas o reproductivas.
- Cáncer ginecológico: Diagnóstico temprano y manejo de enfermedades malignas que afectan cuello uterino, ovarios o endometrio.
El diagnóstico temprano realizado por un ginecólogo en Lima es clave para evitar complicaciones y garantizar un tratamiento oportuno. Por ello, acudir regularmente a una clínica de ginecología permite mantener un adecuado control de la salud.
¿Cuándo acudir a un ginecólogo o ginecóloga en Lima?
Saber cuándo acudir a un ginecólogo o ginecóloga en Lima es fundamental para prevenir enfermedades y mantener una buena salud ginecológica.
Se recomienda acudir a una clínica ginecológica en Lima en los siguientes casos:
- Primera consulta ginecológica (adolescencia): Establecer hábitos de cuidado, recibir educación sexual y realizar exámenes preventivos iniciales.
- Controles preventivos anuales: Chequeos regulares para detectar a tiempo cualquier alteración ginecológica y mantener la salud íntima.
- Dolor pélvico o menstrual intenso: Evaluación de causas como endometriosis, quistes ováricos o trastornos hormonales.
- Flujo vaginal anormal: Detección de infecciones, inflamaciones o cambios que puedan indicar problemas de salud.
- Sangrados irregulares: Identificación de causas de sangrado fuera del ciclo normal y tratamiento oportuno.
- Sospecha de embarazo: Confirmación, control y orientación prenatal desde etapas tempranas.
- Dificultad para concebir: Evaluación integral de fertilidad y planificación de estrategias médicas o reproductivas.
- Molestias durante las relaciones sexuales: Diagnóstico de infecciones, problemas hormonales o condiciones que afectan la salud sexual.
La atención oportuna en una clínica de ginecología permite que un ginecólogo en Lima detecte cualquier problema a tiempo y brinde el tratamiento adecuado.
¿Cada cuánto debes visitar una clínica ginecológica?
La frecuencia de visita a una clínica ginecológica en Lima depende de la edad, antecedentes médicos y estado de salud de cada paciente. Sin embargo, en términos generales, se recomienda acudir al ginecólogo o ginecóloga al menos una vez al año.
En algunos casos, como pacientes con enfermedades previas, embarazo o tratamientos en curso, el ginecólogo en Lima puede indicar controles más frecuentes. Este seguimiento permite prevenir complicaciones y mantener un adecuado estado de salud.
¿Cómo elegir una buena clínica ginecológica en Lima?
Elegir una clínica ginecológica en Lima adecuada es clave para garantizar una atención médica segura y de calidad. No todas las clínicas ofrecen el mismo nivel de servicio, por lo que es importante considerar ciertos factores.
Entre los aspectos más importantes destacan:
- Experiencia del equipo de ginecólogos y ginecólogas en Lima: Profesionales capacitados con trayectoria en diagnóstico, tratamiento y procedimientos ginecológicos avanzados.
- Tecnología y equipos disponibles: Herramientas modernas que permiten realizar exámenes y procedimientos con mayor precisión y seguridad.
- Variedad de servicios ginecológicos: Disponibilidad de consultas, controles preventivos, procedimientos médicos y quirúrgicos, y atención integral.
- Opiniones de pacientes: Testimonios y referencias que reflejan la calidad del servicio y la satisfacción de quienes ya han recibido atención.
- Atención personalizada: Trato cercano y adaptado a las necesidades específicas de cada paciente, fomentando confianza y comodidad.
Una buena clínica de ginecología debe ofrecer un enfoque integral, combinando experiencia médica, tecnología moderna y un trato cercano hacia la paciente.
¿Cuál es la mejor clínica ginecológica en Lima?
Determinar cuál es la mejor clínica ginecológica en Lima puede depender de diversos factores, como la calidad del equipo médico, la experiencia del ginecólogo o ginecóloga, la tecnología utilizada y la satisfacción de las pacientes.
Sin embargo, distintos medios, blogs especializados y la experiencia de pacientes destacan a la Clínica Ginecológica GINECIRUGIA: Ginecología en Lima como una de las principales referencias en el cuidado de la salud femenina.
La Clínica Ginecológica GINECIRUGIA: Ginecología en Lima es reconocida por ofrecer atención especializada, tecnología moderna y un enfoque integral en el diagnóstico y tratamiento de enfermedades ginecológicas. Su equipo de ginecólogos y ginecólogas en Lima altamente capacitados permite brindar soluciones seguras y efectivas para cada paciente.
Además, la Clínica Ginecológica GINECIRUGIA: Ginecología en Lima destaca por su trato cercano, personalizado y su seguimiento continuo, aspectos fundamentales al momento de elegir una clínica de ginecología.
¿Qué diferencia a una clínica ginecológica moderna?
Una clínica ginecológica moderna en Lima se caracteriza por integrar tecnología avanzada con la experiencia de un ginecólogo o ginecóloga en Lima, ofreciendo diagnósticos más precisos y tratamientos más seguros.
Entre sus principales características se encuentran:
- Equipos médicos de última generación: Tecnología avanzada que permite realizar exámenes y procedimientos con mayor exactitud y seguridad.
- Diagnóstico rápido y preciso: Evaluaciones eficientes que facilitan la detección temprana de patologías ginecológicas.
- Tratamientos personalizados: Planes médicos adaptados a las necesidades individuales de cada paciente.
- Procedimientos mínimamente invasivos: Intervenciones que reducen el tiempo de recuperación y disminuyen riesgos.
- Seguimiento continuo: Control post-tratamiento para asegurar resultados óptimos y prevenir complicaciones.
Esto permite que la ginecología en Lima evolucione hacia una atención más eficiente, segura y centrada en la paciente.
Beneficios de acudir a una clínica ginecológica en Lima
Acudir a una clínica ginecológica en Lima ofrece múltiples beneficios para la salud femenina:
- Detección temprana de enfermedades: Permite identificar patologías antes de que progresen, aumentando la eficacia del tratamiento.
- Tratamientos oportunos: Intervenciones rápidas que reducen complicaciones y mejoran los resultados de salud.
- Atención especializada por un ginecólogo en Lima: Profesionales con formación y experiencia que garantizan un cuidado integral y personalizado.
- Mayor precisión en diagnósticos: Uso de tecnología avanzada y protocolos actualizados para resultados confiables.
- Seguimiento personalizado: Monitoreo continuo del estado de salud para asegurar la efectividad de los tratamientos y prevenir recurrencias.
Estos beneficios hacen que la visita regular a una clínica de ginecología sea fundamental para mantener una buena calidad de vida.
Síntomas de alerta que requieren atención ginecológica inmediata
Existen síntomas que requieren atención inmediata por parte de un ginecólogo o ginecóloga en Lima:
- Dolor pélvico intenso: Puede indicar infecciones, quistes ováricos, endometriosis u otras condiciones que necesitan evaluación inmediata.
- Sangrado abundante o irregular: Alteraciones que requieren diagnóstico rápido para descartar problemas como fibromas, trastornos hormonales o lesiones.
- Flujo con mal olor: Señal de infecciones bacterianas o micóticas que necesitan tratamiento oportuno.
- Picazón o ardor vaginal: Síntomas que pueden reflejar infecciones o inflamaciones y requieren atención profesional.
- Dolor durante relaciones sexuales: Puede estar relacionado con infecciones, sequedad vaginal o condiciones ginecológicas que necesitan estudio especializado.
Ante cualquiera de estos síntomas, es importante acudir a una clínica ginecológica en Lima para recibir un diagnóstico oportuno.